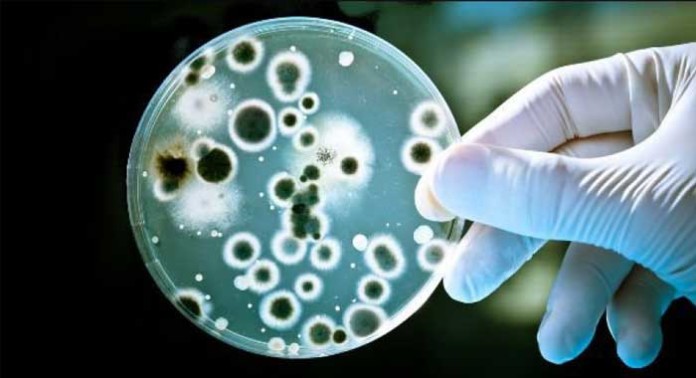

En un nuevo estudio, los investigadores proponen por primera vez que Porphyromonas gingivalis – la bacteria causante de la enfermedad de las encías – podría ser un factor de riesgo para el cáncer de esófago.
Los investigadores, de la Universidad de Louisville (UofL), KY, y la Universidad de Henan de Ciencia y Tecnología en Luoyang, China, informan sobre sus hallazgos en la revista Agentes Infecciosos y Cáncer.
De acuerdo con los Centros para el Control y Prevención de Enfermedades (CDC), cada año, alrededor de 15.000 personas en los EE.UU. son diagnosticadas con cáncer de esófago – un cáncer que comienza en el esófago, el tubo muscular que transporta el alimento desde la garganta hasta el estómago .
El revestimiento del esófago se compone de dos tipos de células, por lo que hay dos tipos principales de cáncer de esófago: adenocarcinoma de esófago y carcinoma esofágico de células escamosas (CECA). CECA es más común en los países en desarrollo.
Los factores de riesgo conocidos para el cáncer de esófago incluyen la exposición química, la dieta, la herencia y la edad – todos los factores ya comunes a muchos otros tipos de cáncer.
El cáncer es difícil de diagnosticar en las primeras etapas. Para muchos pacientes, el cáncer se desarrolla rápidamente después del diagnóstico y el pronóstico no es bueno.
Para su estudio, el equipo probó tejido de 100 pacientes con CECA y 30 pacientes que no tenían la enfermedad (los controles).
Se ensayaron muestras tomadas de tres tipos de tejido esofágico: tejido canceroso, tejido no canceroso adyacentes al tejido canceroso y tejido normal de los controles.
Bacteria presente en 61% de las muestras de tejidos cancerosos
El equipo encontró que la bacteria P. gingivalis estuvo presente en el 61% de las muestras de tejidos cancerosos y sólo el 12% de las muestras de tejido adyacente. Ellos no encontraron ninguno en las muestras de tejido normal.
El co-autor del estudio, Huizhi Wang, profesor asistente de inmunología oral y enfermedades infecciosas de la Facultad de Odontología UofL, dice:
«Estos resultados proporcionan la primera evidencia directa de que la infección podría ser un nuevo factor de riesgo para la CECA, y también puede servir como un biomarcador de pronóstico para este tipo de cáncer.»
Señala que si se confirman estos resultados, entonces se podría decir que la erradicación de una bacteria común oral podría ayudar a reducir el número considerable de personas que desarrollan la CECA.
Para detectar P. gingivalis en las muestras de tejido, los investigadores midieron la expresión de la lisina-gingipain, una enzima única para la bacteria. También buscaron rastros de ADN de la célula bacteriana.
Ellos encontraron niveles, tanto de la enzima y el ADN bacteriano, significativamente mayores en el tejido canceroso de pacientes CECA, que en el tejido circundante o el tejido de los controles normales.
El equipo encontró que los niveles de P. gingivalis medidos estaban en consonancia con los niveles de otras medidas, como la extensión de la diferenciación de las células del cáncer, metástasis (extensión de la propagación) y la tasa de supervivencia global.
Al especular sobre las posibles explicaciones, el profesor Wang ofrece dos. Cualquiera de las células CECA son un «nicho preferido» para la bacteria prosperar, o la infección con la bacteria, de alguna manera, estimula el desarrollo del cáncer.
Si la razón es que las células cancerosas ofrecen a la bacteria un nicho, a continuación, los antibióticos simples podrían ser un camino a seguir para el tratamiento. Otro enfoque podría ser el uso de la tecnología genética para dirigir la bacteria y finalmente eliminar las células cancerosas.
El Prof. Wang dice que está encaminado a favorecer los estudios que prueban realmente que P. gingivalis provoca la CECA, a continuación, la implicación sería enorme, y:
«Se sugiere que la mejora de la higiene oral puede reducir el riesgo de la CECA; la detección de P. gingivalis en la placa dental puede identificar sujetos susceptibles, y el uso de antibióticos u otras estrategias anti-bacterianas puede prevenir la progresión de la CECA.»
Datos básicos sobre el cáncer de esófago:
- El riesgo de desarrollar cáncer de esófago aumenta con la edad;
- Menos del 15% de los casos se producen en personas menores de 55 años;
- La enfermedad es de tres a cuatro veces más común en hombres que en mujeres.







